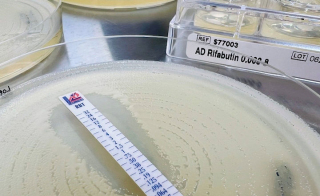
New Agents and Devices for Antimicrobial Susceptibility Testing on Show at ESCMID 2026

As the world's leading clinical microbiology and infectious diseases conference, ESCMID brings together specialists from related fields to exchange knowledge and showcase the latest discoveries. Discover highlights of the trade stands at ESCMID 2026. Explore the latest updates. This year, the focus is efficiency, whether through automation, improved workflows such as self-testing, or more accurate results the first time around.
Puritan provides a wide range of specimen collection tools, including patented PurFlock Ultra® and HydraFlock® flocked swabs, offering superior specimen absorption and efficient elution compared to traditional spun fiber swabs, plus transport solutions to preserve sample integrity from collection to analysis.
Copan announces UBM™, a next-generation transport media designed specifically for molecular testing procedures. Because UBM contains no hazardous compounds, it is easier to handle, store, and ship while still providing reliable nucleic acid preservation.UBM assists labs in concentrating resources on precise, rapid diagnostic results by eliminating unnecessary complexity at the preanalytical stage.
The emergence of self-collection is one of the most interesting developments in diagnostics. Allowing patients to collect samples on their own helps healthcare systems reduce strain on medical resources, improve patient access and convenience, and, when done correctly, maintain reliable, high-quality results. Medical Wire will be showcasing its U-SWAB™ self-collection devices at ESCMID.
The only commercial media produced under true pre-reduced, anaerobically sterilised conditions is Biolog's TruPRAS™ media, which prevents the production of hazardous byproducts that may be dangerous to anaerobic organisms. FDA-approved and well-established for In Vitro Diagnostic (IVD) use, this series of media products has now received CE marking in accordance with EU IVDR regulation 2017/746.
At the Liofilchem booth, there will be an opportunity to discuss their wide range of solutions for Antimicrobial Susceptibility and Resistance Testing, including MTS™ for measuring MIC, ComASP® panels, antibiotic and antifungal discs, agar dilution kits for Fosfomycin and Mecillinam, and more, and Derma-SR-screen, a device for terbinafine and itraconazole susceptibility testing of dermatophytes. A device for terbinafine and itraconazole susceptibility testing of dermatophytes.
Visitors to the Gold Standard Diagnostics Booth can discover their most recent solutions, such as: blot and ELISA assays for hormone and infectious disease detection, the completely automated sample-to-result real-time PCR platform, GENEQUALITY® 2050, modern molecular diagnostic tools, serazym gastroenterology tests intended for specific uses, oncology testing using the novel mir|detect PCR-based assay, and veterinary diagnostic solutions from VetLine.
Bruker's Microbiology and Infection Diagnostics division announces the launch of MyGenius PRO® at ESCMID 2026. Developed in collaboration with ELITechGroup, a Bruker company, and Hitachi High Tech-Corporation, MyGeniusPRO is a fully automated sample-to-answer (S2A) molecular diagnostics system based on PCR technology, which enhances laboratory efficiency and supports high-throughput testing needs. Bruker will also showcase significant advancements in its MALDI Biotyper® and IR Biotyper® workflows.
Find Out More
Find Out More
Find Out More
Find Out More
Find Out More
Find Out More
Find Out More
Find Out More
Find Out More